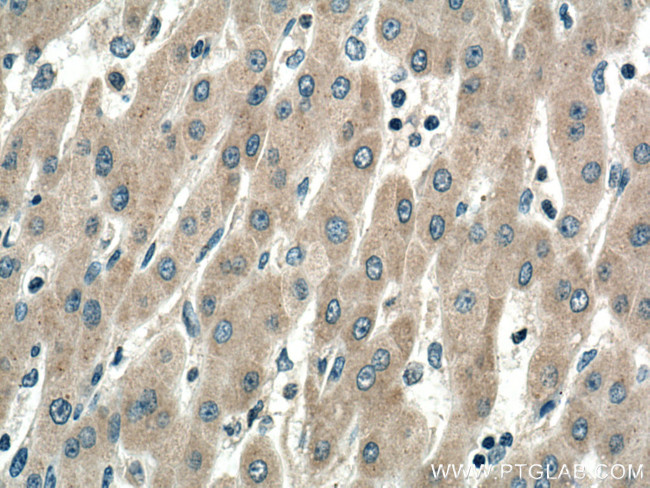
SIRT5 Antibody in Immunohistochemistry (Paraffin) (IHC (P))

Search
Proteintech
SIRT5 Monoclonal Antibody (1F2B2)
{{$productOrderCtrl.translations['antibody.pdp.commerceCard.promotion.promotions']}}
{{$productOrderCtrl.translations['antibody.pdp.commerceCard.promotion.viewpromo']}}
{{$productOrderCtrl.translations['antibody.pdp.commerceCard.promotion.promocode']}}: {{promo.promoCode}} {{promo.promoTitle}} {{promo.promoDescription}}. {{$productOrderCtrl.translations['antibody.pdp.commerceCard.promotion.learnmore']}}
产品信息
67257-1-IG
种属反应
宿主/亚型
分类
类型
克隆号
抗原
偶联物
形式
浓度
纯化类型
保存液
内含物
保存条件
运输条件
产品详细信息
Aliquoting is unnecessary for -20°C storage.
靶标信息
SIRT5 is a human member of a family of proteins called Sirtuins (Sir2-like proteins) and are present in prokaryotes and eukaryotes. All Sir2-like proteins have a sirtuin core domain, which contains a series of sequence motifs conserved in organisms ranging from bacteria to humans. Bacterial, yeast and mammalian sirtuins are able to metabolize NAD and possibly at as mono-ADP-ribosyltransferases. The enzymatic function of sirtuins is not yet completely understood but recent reports of histone-activated Sir2-mediated NAD metabolism and NAD-activated Sir2-mediated histone deacetylation suggest a possible coupled reciprocal activation mechanism involving interactions of Sir2 with NAD and the N epsilon-acetyl-lysine groups of acetylated histones.
仅用于科研。不用于诊断过程。未经明确授权不得转售。
生物信息学
蛋白别名: FLJ36950; NAD-dependent deacetylase sirtuin-5; NAD-dependent lysine demalonylase and desuccinylase sirtuin-5, mitochondrial; NAD-dependent protein deacylase sirtuin-5, mitochondrial; Regulatory protein SIR2 homolog 5; silent mating type information regulation 2, S.cerevisiae, homolog 5; sir2-like 5; SIR2-like protein 5; SIRT5; sirtuin type 5
基因别名: SIR2L5; SIRT5
UniProt ID: (Human) Q9NXA8
Entrez Gene ID: (Human) 23408